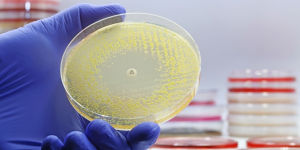

Er der nogen af tegnene, du kan genkende?
Psykologer afslører en række overraskende tegn på over gennemsnittet intelligens, med fokus på egenskaber som følelsesmæssig intelligens, tilpasningsevne og kritisk tænkning frem for kun en traditionel IQ-scorer.
Dr. Jeremy Dean, der er skribent om psykologi på hjemmesiden spring.org.uk har således været en tur i videnskabens dybe kar og fundet frem til fire ting, der kan indikere, at din intelligens er noget over gennemsnittet.
1. Nysgerrighed og åbenhed
En umættelig lyst til viden og en oprigtig interesse i at forstå verden omkring dem kendetegner intelligente mennesker. De nyder at udforske nye områder – ofte uden for deres ekspertise – og elsker at løse komplekse problemer eller opklare mysterier.
Desuden viser de en bemærkelsesværdig åbenhed, hvor de er villige til at revidere deres holdninger og overveje forskellige perspektiver. I stedet for at holde fast i gamle overbevisninger, ser de nye ideer som muligheder for vækst og en dybere forståelse af verden.
2. Følelsesmæssig intelligens og empati
Følelsesmæssig intelligens og empati er afgørende træk ved over gennemsnittet intelligente mennesker. Evnen til at genkende, forstå og regulere egne og andres følelser gør dem i stand til at navigere gennem sociale komplekse situationer effektivt. Det skriver mediet Welingelichte Kringen.
I stedet for at reagere impulsivt i pressede situationer tager de et skridt tilbage, lytter opmærksomt og søger konstruktive løsninger. Ægte empati handler ikke kun om medlidenhed, men om en dyb forståelse for andres følelser, hvilket gør dem særligt dygtige til at opbygge og vedligeholde relationer.
3. Tilpasningsevne og modstandsdygtighed
I en verden, der konstant forandrer sig, skiller intelligente mennesker sig ud med deres ekstraordinære tilpasningsevne. De ser forandringer som muligheder for vækst og læring, og ikke som trusler.
Uanset om det handler om at skifte karriere eller lære ny teknologi, formår de at vende udfordringer til muligheder. Denne fleksibilitet suppleres af en imponerende modstandsdygtighed.
Når de står over for modgang, fortsætter de ufortrødent og ser fiaskoer som værdifulde læringsoplevelser. Denne kombination gør dem i stand til at trives under udfordrende forhold.
4. Selvbevidsthed og kritisk tænkning
Selvindsigt og et skarpt analytisk sind er kendetegnende for intelligente mennesker. De har en dyb forståelse af deres egne styrker og svagheder, hvilket giver dem mulighed for at træffe velovervejede beslutninger og interagere mere effektivt med andre.
Denne introspektive evne går hånd i hånd med et veludviklet kritisk tænkende sind. De stiller spørgsmål, nedbryder forudfattede ideer og adskiller fakta fra holdninger – en vigtig færdighed i en informationsmættet verden.
Kombinationen af selvbevidsthed og kritisk analyse gør dem i stand til at udvikle innovative løsninger og tackle komplekse problemer fra flere vinkler.